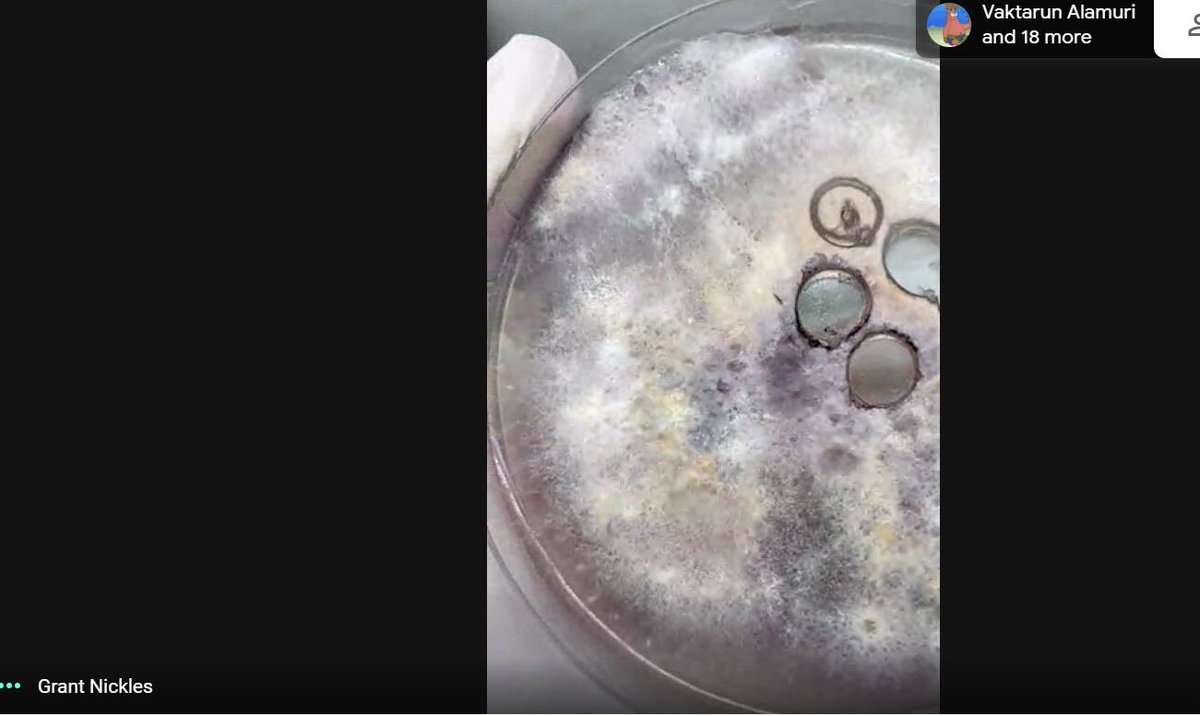
KlostermanMegan's tweet image. 6th grade BVA students had the pleasure of having a guest speaker today! Grant is getting his PhD in Cellular and Molecular biology and shared his awesome fungi with us! #futurescientists  #ihpromise @IHMiddle @BraveVirtual

BraveVirtualAcademy
@BraveVirtual
Brave Virtual Academy is our new learning option for Indian Hill families wanting to study in a flexible, online environment.
Potrebbero piacerti
Braves! It’s out to happen! Let’s go, Class of 2021! #IHPromise




The BVA send off was such a great event! Better than the event itself: our fabulous BVA teachers and all of their dedication this year! It’s been a tremendous year of learning and growth! @DrKimGiven @BraveVirtual #seethepossibilities @IHSchools

I had the honor of seeing and hearing just a few of these brand new books published by our #PSBVA learners!!! Scholarship at its finest. #IHPromise
The 2nd graders in 2R are experts on many topics! Choosing the text structure they felt was best for their topic and being able to create on @BookCreatorApp was powerful for these young authors! @IHPrimary #IHPromise #IHBVA




They did it! Completed the requirements for 8th grade graduation! #IHPromise



So proud of this whole #IHBVA team. Their work has been incomparable, unparalleled, inconceivable!! It’s been an honor. #IHPromise ❤️❤️❤️
Our teachers have done amazing things this year! Congratulations to all our BVA faculty! @DrKimGiven @BraveVirtual #IHPromise


So proud of you, your hard work, and positive attitude, Betty. Thank you for embodying what it means to have student agency! #IHPromise
We love that our @BraveVirtual @IHMiddle student Betty Crabbe has used time this year to research what it will take to be a future congresswoman! Betty says about being virtual: "I enjoyed getting to spend more time with my family." We are so happy you got to, too! #IHPromise

This morning we celebrate our IHHS Underclass Awards Ceremony - live-streaming for parents & our @BraveVirtual students! #IHPromise @IHHSPrincipal @IHHSCounseling

6th grade BVA students had the pleasure of having a guest speaker today! Grant is getting his PhD in Cellular and Molecular biology and shared his awesome fungi with us! #futurescientists #ihpromise @IHMiddle @BraveVirtual

❤️❤️❤️
@ ERobbPrincipal RT @LRobbTeacher: As we re-imagine school, keep this in mind and develop a student-centered approach so students have voice, choice, and develop agency! @ERobbPrincipal

Twenty-six studies point to more play-based learning for young children hechingerreport.org/twenty-six-stu…
hechingerreport.org
Twenty-six studies point to more play-based learning for young children
Play-based learning has the potential to reduce inequality, report finds
Yea, Penny! So proud of you for exhibiting strong leadership and serving as a model for others. EduHERO, indeed!!!
Congrats to @IHElementary @BraveVirtual student Penny Bruck - our May EduHERO! Penny is kind, thoughtful, & hardworking with a positive attitude! We are so lucky to have Penny in our community! Our @ihsuperbrave presented Penny with her special recognition virtually! #IHPromise

Today I celebrate my amazing, one of a kind, @IHSchools Director of Communications, Heather Higdon! Thank you for all you do! #IHPromise #SchoolPRDay @OHSPRA @NSPRA

Our BVA students dropped by and a friend had a note for me. There really is nothing like the love for your first teacher virtual or in person #IHPromise #BetterTogether #BeBrave

ES Specialists are getting ready for our first virtual SHINE night! Will you be able to solve the Escape Room puzzles and breakout? Check your UA Google Classroom stream for the Zoom link. See you soon! @IHElementary #IHPromise

"Education is about elevation. Not only of our students but of one another. " A Fear of Success and the Elevation of Others buff.ly/3b2NKtY

Hey, Teachers of #IHBVA! It's Day #3 of Educator Appreciation Week. Did you know that over 60 @IHSchools Teachers were involved in making BVA a success? Yesterday may have been #StarWarsDay but we think you are "out of this world" on EVERY day! #IHPromise
United States Tendenze
- 1. #AEWDynamite N/A
- 2. Andrade N/A
- 3. Ciampa N/A
- 4. #TheMaskedSinger N/A
- 5. Cavs N/A
- 6. Jaylon Tyson N/A
- 7. #SistasOnBET N/A
- 8. #ChicagoFire N/A
- 9. Thekla N/A
- 10. Allie N/A
- 11. Doyle N/A
- 12. Nicki N/A
- 13. Bronny N/A
- 14. #ChicagoPD N/A
- 15. Cleveland N/A
- 16. Optimus N/A
- 17. Swerve N/A
- 18. Giannis N/A
- 19. Fulton County N/A
- 20. Rand Paul N/A
Something went wrong.
Something went wrong.





































































































